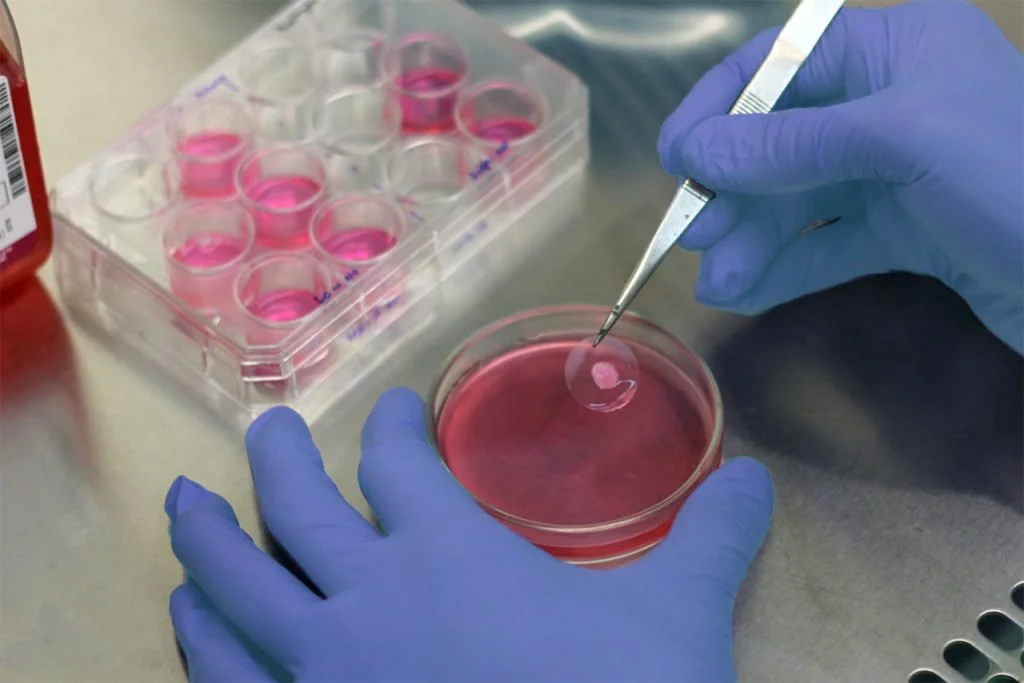

Bio-Artificial Liver
Dr. Kenneth Matsumura was acclaimed as Inventor of the Year by TIME Magazine for his invention of the Bio-Artificial Liver.
After 25 years of intensive research, there is still no effective treatment for liver failure. The liver is one of the most complex organs in the body—and one of the hardest to replace. It performs a variety of functions, and many of them are still poorly understood. It removes toxins from the blood and manufactures up to 1,000 proteins, metabolites and other vital substances. Now scientists trying to develop an artificial liver have found a way around these complexities: they let rabbit-liver cells do the work. The Bio-Artificial Liver developed by Dr. Kenneth Matsumura has a two-part chamber—patient's blood on one side, live rabbit cells suspended in a solution on the other—with a semipermeable membrane in between. As toxins from the blood pass through the membrane, the rabbit cells metabolize them and send the resulting proteins and other good things back to the other side, permitting the cells to detoxify the user’s blood just like a natural liver. Because the rabbit cells never come into direct contact with human blood, the chances of infection or rejection are minimized. The device is meant primarily as a bridge to an eventual liver transplant for patients with acute liver failure or for those who have rejected a previous transplant. In some cases, it may also give a damaged liver time to heal on its own, eliminating the need for a transplant altogether. Disposable units can be used for a series of brief treatments, as with kidney dialysis, creating a liver “dialysis” machine.
Dr. William L. Hamilton was an essential part of the laboratory team in the pioneering work of the artificial liver.
The bio-artificial liver exemplifies the dream of ALIN Foundation's founders — innovative technology bringing hope where none existed before. The bio-artificial liver was recognized as an Invention of the Year by TIME Magazine.
-
The Breakthrough
Dr. Matsumura designed a device that uses liver cells grown in a culture—containing both biological and manufactured components. Blood circulates through the external device, using a synthetic membrane to separate live animal cells. The membrane prevents rejection, but allows the cells to detoxify the blood.
-
Clinical Trials
The machine uses a rocking motion — 15 seesaws per minute — to bathe the liver cells in nutrients so they can survive longer and function better. During the clinical trials, cells remained fully active in the reservoir for 48 straight hours of blood detoxification, keeping the liver cells metabolically viable for up to a month.
-
Collaborative Research
ALIN and MIT collaborated on a device with a reservoir filled with a highly oxygenated liquid medium into which 500 grams of live pig hepatocytes were deposited. Blood courses through membranes, while immersed in the liquid, allowing blood to flow in and out while the hepatocytes remove bile, ammonia, urea, and other impurities.
Collaboration Continues
“Great things are never done by one person, but by a team of people”
Dr. Kenneth Matsumura, Chairman of ALIN Foundation